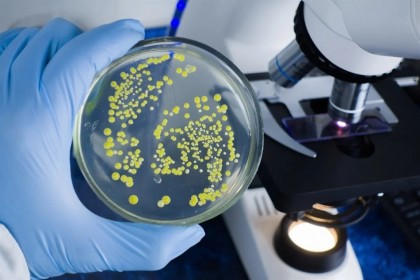
Transplantul fecal - un tratament eficient pentru infecțiile cu C. difficile

Transplantul fecal - un tratament eficient pentru infecțiile cu C. difficile
©
Autor: Airinei Camelia
C. difficile este un organism bacterian care poate provoca diaree potențial fatală, în special la persoanele cu disbioză microbiană. Abordarea convențională pentru tratarea ICD implică antibiotice, care pot agrava și mai mult modificările microbiene intestinale. Transplantul de microbiotă fecală poate fi, de asemenea, utilizat pentru a gestiona ICD prin restabilirea echilibrului microbiomului intestinal. Cu toate acestea, sunt necesare cercetări suplimentare, inclusiv studii randomizate controlate, pentru a evalua raportul risc-beneficiu al transplantului fecal în ceea ce privește managementul IrCD.
Prezenta revizuire sistematică analizează datele existente despre transplantul fecal ca opțiune de management pentru IrCD în comparație cu abordările de tratament convenționale, inclusiv antibioticele. Echipa a folosit metode Cochrane standard și extinse pentru căutarea datelor relevante până la 31 martie 2022. Numai studiile randomizate controlate, inclusiv pacienți copii și/sau adulți cu IrCD, au oferit intervenții care îndeplinesc criteriile transplantului fecal.
Un total de șase studii au fost luate în considerare pentru revizuirea finală, care a constat din 320 de adulți. Aceste studii au fost efectuate în mai multe țări, inclusiv Italia, Danemarca, Țările de Jos, Statele Unite și Canada. Patru studii au fost efectuate la un singur centru, în timp ce două studii au fost efectuate în mai multe centre.
Siguranța și eficacitatea transplantului fecal în tratarea IrCD au fost evaluate în toate studiile randomizate controlate incluse. Datele combinate din toate studiile au indicat că transplantul fecal ar putea crește rezoluția IrCD în rândul persoanelor imunocompetenți în comparație cu martorii. Valorile rapoartelor de risc (RR) și intervențiilor necesare pentru un rezultat benefic suplimentar (NNTB) au fost 1,9, respectiv, 3,0. Calitatea dovezilor a fost considerată a fi moderată în studiile incluse.
Important, transplantul de microbiotă fecală a condus la o scădere marginală a evenimentelor adverse grave; cu toate acestea, aceste observații au fost asociate cu estimări ale intervalului de încredere (IC), indicând o certitudine la nivel moderat ale acestor dovezi. Numărul deceselor indiferent de cauză a fost redus după transplantul fecal, cu o certitudine scăzută a dovezilor.
Pe baza acestor constatări, printre pacienții imunocompetenți și adulți cu IrCD, transplantul fecal este mai probabil să rezolve IrCD decât terapiile alternative, inclusiv antibioticele. Au fost raportate doar câteva evenimente adverse și decese indiferent de cauză; prin urmare, dovezi concludente cu privire la siguranța transplantului fecal nu au putut fi obținute. Sunt necesare cercetări suplimentare pentru a evalua riscurile acute și cronice asociate cu administrarea transplantului fecal în rândul pacienților cu IrCD, inclusiv a persoanelor imunosuprimate.
sursa: News Medical
foto: Prrrettty / Shutterstock.com
Data actualizare: 28-04-2023 | creare: 28-04-2023 | Vizite: 716
Bibliografie
Fecal microbiota transplant: Effective solution for recurrent C. difficile infections, link: https://www.news-medical.net/news/20230427/Fecal-microbiota-transplant-Effective-solution-for-recurrent-C-difficile-infections.aspx ©
Copyright ROmedic: Articolul se află sub protecția drepturilor de autor. Reproducerea, chiar și parțială, este interzisă!
Alte articole din aceeași secțiune:
- Antibiotic utilizat în mod obișnuit aduce mai multe complicații și crește riscul de deces la cei mai bolnavi pacienți
- Descoperirea complexului GATE: un mecanism ascuns de infectare al citomegalovirusului
- Prevalența HPV la femeile vaccinate în adolescență: concluzii din studiul Trial23 (Danemarca, 2017–2024)
- Noi descoperiri despre modul în care sistemul imunitar combate paraziții intestinali
Din Biblioteca medicală vă mai recomandăm:
Din Ghidul de sănătate v-ar putea interesa și:
Forumul ROmedic - întrebări și răspunsuri medicale:
Pe forum găsiți peste 500.000 de întrebări și răspunsuri despre boli sau alte subiecte medicale. Aveți o întrebare? Primiți răspunsuri gratuite de la medici.- Infectie cu Clostridium Difficile - (C-diff)
- FMT pentru tratamentul recidivei colitei cu Clostridium Difficile
- Probleme de sanatate - helyobact pylori si clostridium dificile
- Diagnostic dificil - posibil Clostridium difficile